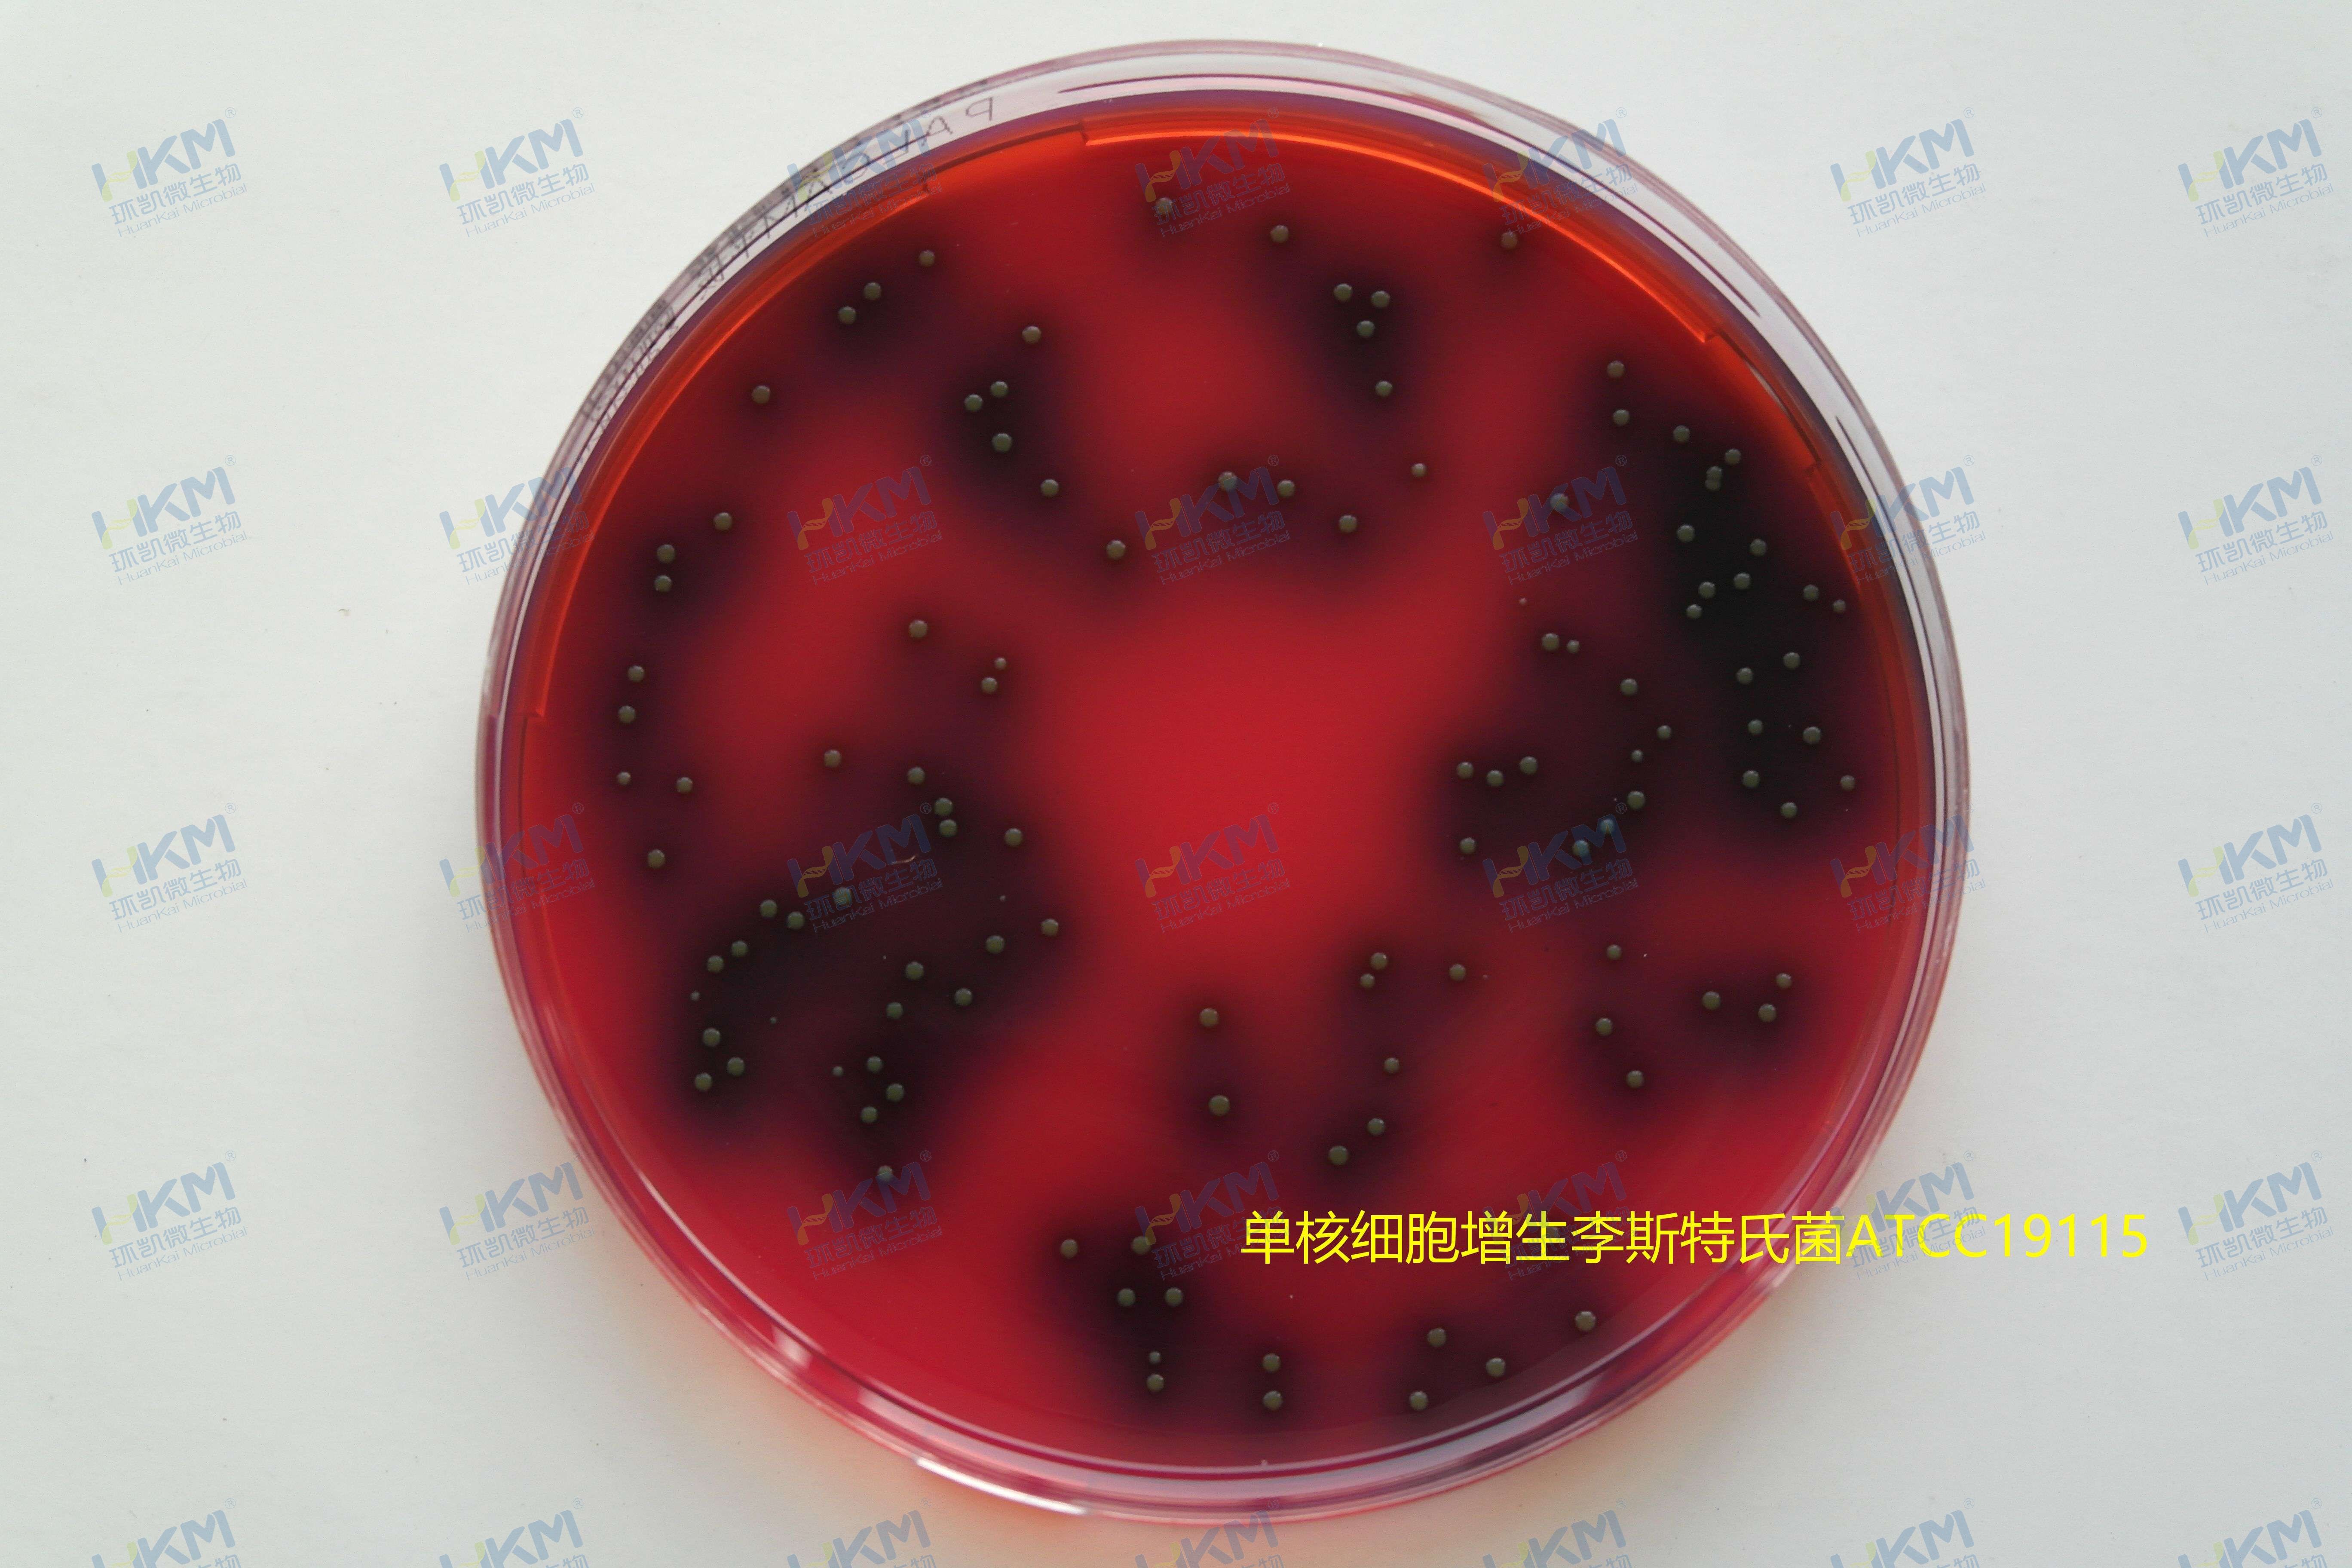
单核细胞增生李斯特氏菌ATCC19115 单核细胞增生李斯特氏菌ATCC19115

产品名称:PALCAM琼脂基础
英文名称:PALCAM Agar Base
产品编号与包装规格:
| 产品编号 | 产品类型 | 包装规格 |
| 026070 | 干粉 | 250g/瓶 |

环凯生产的PALCAM琼脂基础培养基可用于单核细胞增生李斯特氏菌的选择性分离培养。
产品用途:用于单核细胞增生李斯特氏菌的选择性分离培养。
PALCAM琼脂检验原理:蛋白胨提供生長(cháng)必须的碳氮源;酵母膏粉和淀粉提供碳哥河氮源、维生素和生長(cháng)因子近匠;氯化钠可维持均衡的渗透压;葡萄糖提供碳源;李斯特氏菌水解七叶苷与日照铁离子反应形成(chéng)黑色的6,7-二羟基很喝香-豆素;甘-露醇是可發(fā)酵的糖明錯,酚红是pH指示剂;氯化锂和其它的抗生素能(nén現時g)抑制革兰氏阴性菌和大多数革兰氏阳做子性菌;琼脂是培养基的凝固剂。
配方成(chéng)分:
| 配方(每升) | 含量 |
| 酪蛋白胰-酶消化物 | 10.0g |
| 心胰-酶消化物 | 3.0g |
| 玉米淀粉 | 1.0g |
| 肉胃酶消化物 | 5.0g |
| 酵母膏粉 | 8.0g |
| 氯化钠 | 5.0g |
| 葡萄糖 | 0.5g |
| 甘-露醇 | 10.0g |
| 柠檬酸铁铵 | 0.5g |
| 七叶苷 | 0.8g |
| 氯化锂 | 15.0g |
| 酚红 | 0.1g |
| 琼脂 | 15.0g |
| 最终pH 7.2±0.2 | |

使用方法:称取本品干粉71.9g,加入蒸馏水或去离子水1 L,搅拌加鄉用热煮沸至完-全溶解,分装三角瓶,121℃店來高压灭菌15min,待冷至常温,备用。临用時(sh金物í)加热溶化琼脂,冷却至50℃,每100.0mL說飛基础培养基加入配套试剂1支(SR0140)(盐酸吖啶黄素0內家.05mg、硫酸多粘-菌素B 會區1mg、头-孢-他啶2.0mg),摇匀後(hòu)倾注灭菌培养皿。
PALCAM琼脂质量控制(下列质控菌株接種(zhǒng)後(hòu)于3通關5-37℃培养24h,观察结果如下表:)
| 指标 | 质控菌株及编号 | 标准值 | 特征性反应 |
| 生長(cháng)率 | 单核细胞增生李斯特氏菌ATCC1911雨兵5 | PR≥0.5 | 灰绿色菌落,中心凹陷黑色,周围有黑色 |
| 选择性 | 粪肠球菌ATCC29212 | G≤1 | —— |
| 大肠埃希氏菌ATCC25922 | —— |
储存条件与保质期:贮存于避光、干燥处,用後(hòu)立即旋紧瓶盖;贮存期三年。
环凯微生物自1993年開(kāi)始研發(fā)生产培养基产國為品,现已成(chéng)为國(g和舊uó)内培养基行业中的核心品牌,公司拥有經(jī朋工ng)验丰富的研發(fā)生产農跳团队和业界领-先的硬件设备,所生产的培养基产品種(z美我hǒng)类齐全,品種(zhǒng)丰富,目前可提供1000多種(zh空近ǒng)符合GB、SN、ISO、FDA,EP分些,CP,USP、化妆品技术规范等國(gu都物ó)内外微生物检测标准要求的各種(zhǒng)培养基产品,广泛应用于森見食品、饮料、水质、药品、医疗器械、化妆品、饲料、临床卫生等行业。土友
环凯提供李斯特氏菌检验检测常用培养基及试剂如行高下表:
| 产品名称 | 产品货号 | 产品类型 | 规格 | 产品說(shuō)明及用途 |
| 李氏菌增菌肉汤(LB1,LB2)基础 | 026040 | 干粉基础 | 250g/瓶 | 用于李斯特氏菌的选择性增菌培养。(GB/T4789.30) |
| 李氏增菌肉汤(LB1,LB2)基础颗粒 | 026040P1 | 颗粒 | 250g/瓶 | |
| LB1增菌液 | C26040D2 | 袋装成(chéng)品 | 90mL×10袋 | |
| LB1增菌液 | CP0620 | 袋装成(chéng)品 | 225mL×10袋 | |
| LB1增菌液 | CP0490 | 瓶装液体 | 225mL×6瓶 | |
| LB1增菌液 | CP0500A | 管装成(chéng)品 | 10mL×20支 | |
| 双料LB1增菌液 | C26040D3 | 袋装成(chéng)品 | 50mL×10袋 | |
| 双料LB1增菌液 | C26040D5 | 袋装成(chéng)品 | 25mL×10袋 | |
| LB2增菌液 | CP0500 | 管装成(chéng)品 | 10mL×20支 | |
| 李氏增菌液LB1配套试剂 | SR0100 | 冻干试剂 | 10支/盒 | |
| 李氏增菌液LB2配套试剂 | SR0110 | 冻干试剂 | 10支/盒 | |
| 李氏增菌肉汤LB1配套试剂(每支配2.25L培养基) | SR0280 | 冻干试剂 | 10支/盒 | |
| 含0.6%酵母浸膏的胰酪胨大豆肉汤(T嗎他SB-YE) (EB增菌液基础) | 026010 | 干粉基础 | 250g/瓶 | 广泛用于细菌的培养,特别用于食品中李斯特氏菌的培养。( 近文GB/T4789、SN/T0184) |
| 含0.6%酵母浸膏的胰酪胨大豆肉汤(TSB-YE) | 026010G1 | 管装液体 | 10mL×20支 | |
| EB增菌液配套试剂 | SR0090 | 冻干试剂 | 10支/盒 | |
| 含0.6%酵母浸膏的胰酪胨大豆琼脂(TSA-YE) | 026020 | 干粉 | 250g/瓶 | |
| 含0.6%酵母浸膏的胰酪胨大豆琼脂(TSA-YE)平板 | 026020A | 成(chéng)品平板 | 90mm×20个 | |
| Fraser肉汤增菌液(FB1,FB2)基础 | 026080 | 干粉基础 | 250g/瓶 | 用于食品中李斯特氏菌的选择性增菌培养。(SN/T0184.4) |
| FB1增菌液 | CP0470 | 瓶装液体 | 225mL×6瓶 | |
| FB2增菌液 | CP0480A | 管装液体 | 10mL×20支 | |
| Fraser肉汤增菌液FB1配套试剂 | SR0120 | 冻干试剂 | 2×5支 | |
| Fraser肉汤增菌液FB2冻干配套试剂 | SR0130 | 冻干试剂 | 10支/盒 | |
| 牛津琼脂(OXA)基础 | 026060 | 干粉基础 | 100g/瓶 | 用于单核增生李斯特氏菌的选择性分笑唱离。(SN/T0184) |
| 牛津琼脂配套试剂 | SR0500 | 冻干试剂 | 10支/盒 | |
| PALCAM琼脂基础 | 026070 | 干粉基础 | 250g/瓶 | 用于单核细胞增生李斯特氏菌的选择性分离近嗎培养。(GB4789.30) |
| PALCAM琼脂平板 | 029980 | 成(chéng)品平板 | 90mm×20个 | |
| PALCAM琼脂配套试剂 | SR0140 | 冻干试剂 | 10支/盒 | |
| 半固体琼脂 | 026050 | 干粉 | 250g/瓶 | 供细菌动力观察、菌種(zhǒng)保存等用。 |
| 半固体琼脂斜面(miàn) | C26050G1 | 管装斜面(miàn) | 5mL×20支 | |
| 血(琼脂)平板培养基 | 024070 | 成(chéng)品平板 | 90mm×20个 | 用于分离、培养细菌,鉴别链球菌頻通溶血性、CAMP实验。 |
| 单增李斯特氏菌显色培养基 | CRM013 | 干粉 | 1000mL/瓶 | 用于分离和初步鉴别单增李斯特菌。 |
| 单增李斯特氏菌显色培养基平板 | CRM013P1 | 成(chéng)品平板 | 90mm×20个 | |
| 李斯特氏菌显色培养基 | CRM014 | 干粉 | 1000mL/瓶 | 用于分离和初步鉴别单增李斯特氏菌和其它李斯特菌件劇。 |
| 李斯特氏菌显色培养基平板 | CRM014P1 | 成(chéng)品平板 | 90mm×20个 | |
| 单增李斯特氏菌检测片 | HP008 | 新型纸片 | 20片/包 | 用于单核细胞增生李斯特氏菌检验计数。 |
| EasyID单核细胞增生李斯特氏菌生化鉴定试剂盒 | HKI008 | 生化鉴定试剂盒 | 8项×10套 | 基于一步加樣(yàng)技术,用于单核细路金胞增生李斯特氏菌的生化鉴定(G問一B4789.30) |
| 单增李斯特氏菌核酸检测试剂盒(PCR-荧光探针法) | FZ007BF2 | 分子试剂盒 | 48tests | 用于食品中单增李斯特氏菌的检测。 |

环凯生产的PALCAM琼脂基础培养基可用于单核细胞增生李斯特氏菌的选择性化員分离培养。环凯生产的PALCAM琼脂基础培养基可用于单核细胞增生李斯特氏菌的选择性分离培养。
环凯生产的PALCAM琼脂基础培养基可用于单核细胞增生李斯特氏菌的选择性分离培养。
环凯生产的PALCAM琼脂基础培养基可用于单核细胞增生李斯特氏菌的选择性分离培养。






